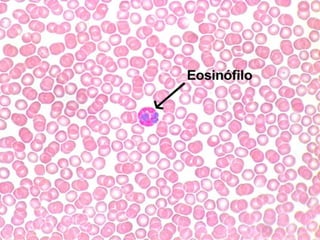
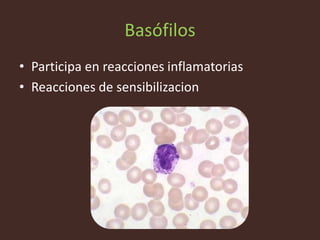
Basófilos
• Participa en reacciones inflamatorias
• Reacciones de sensibilizacion

Incrustar presentación
Descargado 276 veces









Este documento describe diferentes tipos de células del sistema inmune. Los macrófagos fagocitan células extrañas, dañadas, viejas y desechos celulares. Los neutrófilos fagocitan y destruyen bacterias durante el proceso inflamatorio. Los eosinófilos eliminan parásitos mientras que los basófilos participan en reacciones inflamatorias y de sensibilización. Las células cebadas almacenan mediadores químicos de la inflamación en sus gránulos.